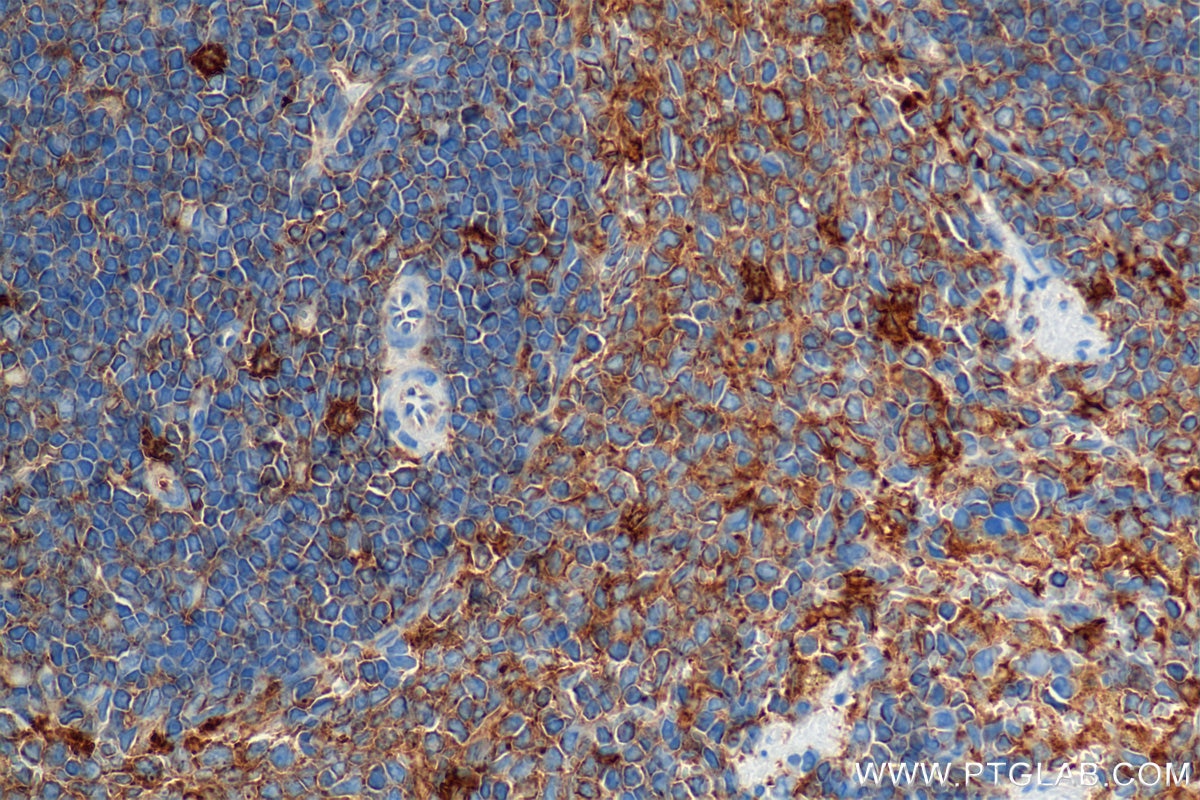
Immunohistochemical analysis of paraffin-embedded rat spleen tissue slide using 84758-5-RR (IL-4RA/CD124 antibody) at dilution of 1:1000 (under 40x lens). Heat mediated antigen retrieval with Tris-EDTA buffer (pH 9.0). This data was developed using the same antibody clone with 84758-5-PBS in a different storage buffer formulation. Immunohistochemistry (IHC) staining of rat spleen tissue using IL-4RA/CD124 Recombinant monoclonal antibody (84758-5-RR)

Validation Data Gallery
Tested Applications
Recommended dilution
| Application | Dilution |
|---|---|
| It is recommended that this reagent should be titrated in each testing system to obtain optimal results. | |
Product Information
84758-5-PBS targets IL-4RA/CD124 in WB, IHC, Indirect ELISA applications and shows reactivity with human, mouse, rat samples.
| Tested Reactivity | human, mouse, rat |
| Host / Isotype | Rabbit / IgG |
| Class | Recombinant |
| Type | Antibody |
| Immunogen |
CatNo: Eg2176 Product name: Recombinant Mouse IL-4RA/CD124 protein (rFc Tag)(HPLC verified) Source: mammalian cells-derived, pHZ-KIsec-C-rFc Tag: C-rFc Domain: 26-233 aa of NM_001008700.3 Sequence: IKVLGEPTCFSDYIRTSTCEWFLDSAVDCSSQLCLHYRLMFFEFSENLTCIPRNSASTVCVCHMEMNRPVQSDRYQMELWAEHRQLWQGSFSPSGNVKPLAPDNLTLHTNVSDEWLLTWNNLYPSNNLLYKDLISMVNISREDNPAEFIVYNVTYKEPRLSFPINILMSGVYYTARVRVRSQILTGTWSEWSPSITWYNHFQLPLIQR 相同性解析による交差性が予測される生物種 |
| Full Name | interleukin 4 receptor, alpha |
| Calculated molecular weight | 88 kDa |
| Observed molecular weight | 130 kDa |
| GenBank accession number | NM_001008700.3 |
| Gene Symbol | Il4ra |
| Gene ID (NCBI) | 16190 |
| Conjugate | Unconjugated |
| Form | |
| Form | Liquid |
| Purification Method | Protein A purfication |
| UNIPROT ID | P16382-1 |
| Storage Buffer | PBS only{{ptg:BufferTemp}}7.3 |
| Storage Conditions | Store at -80°C. |
Background Information
IL-4 receptor alpha chain (IL-4RA), also known as CD124, is a transmembrane glycoprotein expressed on a wide variety of hematopoietic and non-hematopoietic cells. It is a receptor for both IL-4 and IL-13. IL-4RA can complex with the common gamma chain (IL-2R gamma or CD132) and utilizes JAK1 and JAK2 for signal transduction, while complexes of IL-4RA with IL-13RA1 subunit mediate signals via JAK2 and Tyk2. The IL-4 response is involved in promoting Th2 differentiation. The IL-4/IL-13 responses are involved in regulating IgE production and, chemokine and mucus production at sites of allergic inflammation.